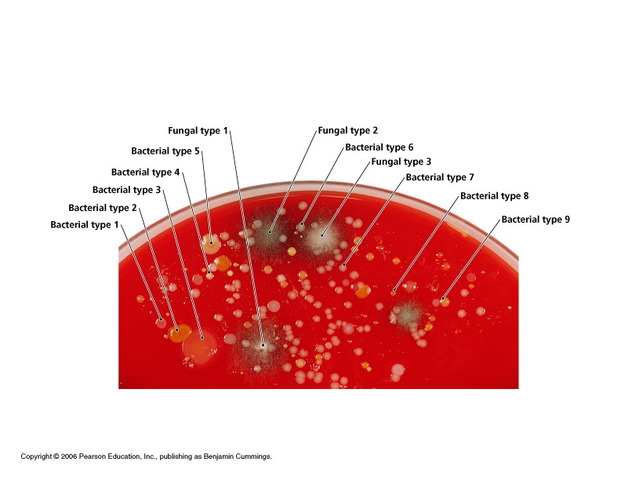
Louis Pasteur and Robert Koch establish the germ theory of disease

-
A Dutch lens maker and his father started experimenting with lenses, putting them in a tube, stacked on each other. The two made an important discovery that the object near the end of the tube appeared larger than it really was, much larger than a magnifying glass made it appear. This was the first compound microscope.
*No month and/or day recorded -
The book published by Harvey explained how blood was pumped from the heart throughout the body, then returned to the heart and recirculated.
*No month and/or day recorded -
A Dutch lens grinder created single lens microscopes which were more superior than the Janssen compound microscope; Van Leeuwenhoek grinded lenses about a millimeter in diameter that could still magnify several hundred times.
*No month and/or day recorded -
Fahrenheit, a German scientist, is credited with the invention of the alcohol thermometer, though he was not the one to first invent it. The scientist was a skilled glassblower and was most likely given credit due to the fact that he produced the world's first reliable thermometer.
*No month and/or day recorded -
Fahrenheit's mercury thermometer consists of a capillary tube which, after being filled with mercury, is heated to expand the mercury and expel the air from the tube. The tube is then sealed, leaving the mercury free to expand and contract with temperature changes.
*No month and/or day recorded -
While it had already been known that lime juice was beneficial to scurvy, Lind experimented with 12 men on his ship--all of which who had scurvy--by changing their diets. The men given oranges and lemons made remarkable recoveries, while the men given other food items did not.
*No month and/or day recorded -
Jenner heard tales that dairymaids who suffered through couwpox would not get smallpox, so, on May 14th, he found a young dairymaid with fresh cowpox lesions; using the matter from the girl's lesions, Jenner innoculated an 8-year-old boy.
-
Unable to feel a patient's heartbeat through his hand, or by pressing his ear to the chest due to the patient's "great degree of fatness," Laennec created the stethoscope. The first stethoscope was a hollow wooden tube, one end would be pressed to the patient's chest, the other end pressed against the doctor's ear.
*No month and/or day recorded -
-
-
-
-
-
-
-
-
-
-
-
-
-
-
-
-
-
-
-
-
-
-
-
-
-
-
-
-
-
-
-
-
-
-
-
-
-
-
-
-
-
-
-
-
-
-
In 1910, Rhazes provided the first medical description of smallpox--rash, progressing to pus-filled blisters, able to result in disfiguration, blindness, and death--and described that it transmitted from person to person.
*No month and/or day recorded
Plan projects on a visual timeline
Map milestones, phases, deadlines, and key events in one place so the sequence is easier to see and share. Timetoast is a timeline maker for work, school, research, and stories.